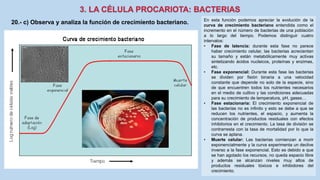
En esta función podemos apreciar la evolución de la
curva de crecimiento bacteriano entendida como el
incremento en el número de bacterias de una población
a lo largo del tiempo. Podemos distinguir cuatro
intervalos:
• Fase de latencia: durante esta fase no parece
haber crecimiento celular, las bacterias acrecientan
su tamaño y están metabólicamente muy activas
sintetizando ácidos nucleicos, proteínas y enzimas,
etc.
• Fase exponencial: Durante esta fase las bacterias
se dividen por fisión binaria a una velocidad
constante que depende no solo de la especie, sino
de que encuentren todos los nutrientes necesarios
en el medio de cultivo y las condiciones adecuadas
para su crecimiento de temperatura, pH, gases…
• Fase estacionaria: El crecimiento exponencial de
las bacterias no es infinito y esto se debe a que se
reducen los nutrientes, el espacio, y aumenta la
concentración de productos residuales con efectos
inhibitorios en el crecimiento. La tasa de división se
contrarresta con la tasa de mortalidad por lo que la
curva se aplana.
• Muerte celular: Las bacterias comienzan a morir
exponencialmente y la curva experimenta un declive
inverso a la fase exponencial. Esto es debido a que
se han agotado los recursos, no queda espacio libre
y además se alcanzan niveles muy altos de
productos residuales tóxicos e inhibidores del
crecimiento.
20.- c) Observa y analiza la función de crecimiento bacteriano.

Este documento presenta información sobre la biología celular y molecular. Explica los niveles de organización en los seres vivos, centrándose en el nivel celular y molecular. Incluye temas como la teoría celular, los tipos de células (procariotas y eucariotas), el ciclo celular, la nutrición y relación celular, y microorganismos causantes de enfermedades. También proporciona enlaces a páginas web para realizar un cuestionario sobre estos temas.